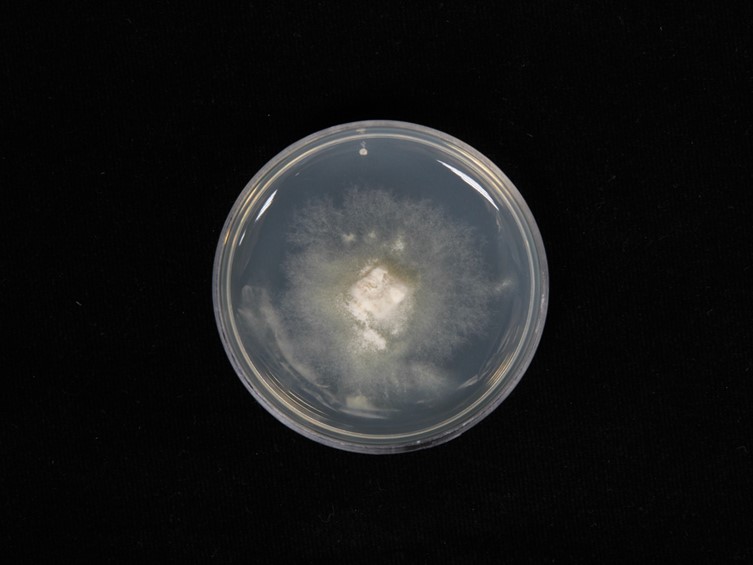

Holotype:
THAILAND, Chiang Mai Province, Saluangnok community forest, 8 Oct. 2019, U. Pinruan, S. Sommai, P. Khamsuntorn, holotype BBH 47825, ex-type living culture BCC 92054.
Habitat:
Solitary or scattered on soil, under Bambusa sp.
Description:
 Egg globose to subglobose, 22-30 mm in diam, white with a white mycelial rhizomorph arising from the base. Exoperidium papery, milky white; mesoperidium gelatinous or lightly viscous, transparent to subtransparent, 3.5-5 mm thick, moderate yellowish-brown; endoperidium membranous, thin, white, covering an upper surface of gleba.
Egg globose to subglobose, 22-30 mm in diam, white with a white mycelial rhizomorph arising from the base. Exoperidium papery, milky white; mesoperidium gelatinous or lightly viscous, transparent to subtransparent, 3.5-5 mm thick, moderate yellowish-brown; endoperidium membranous, thin, white, covering an upper surface of gleba.  Mature basidiomata 205-215 mm high. Cap campanulate, 40-50 mm high, 35-45 mm wide, surface strongly reticulate, light yellow, meshes deep, polygonal, apex with an apical pore and covered with greenish-white membrane approximately ¼ the size of the cap. Gleba moderate olive-brown, mucilaginous. Pseudostipe 158-165 mm high, cylindrical, tapering toward the apex, 20-25 mm wide at the base, 10-13 mm wide at the apex, white, fragile and soft, spongy, hollow. Indusium coarsely latticed, white, extended to ¾ the size of the pseudostipe. The meshes of indusium are large, hexagonal or polygonal, 5-10 mm wide. Volva globose to subglobose, 55 × 40 mm in diam, light brownish gray, smooth surface, Rhizomorphs white, when scratched the color changes to light purple. Odor fetid. Basidia 7.0-15.0 × 1.5-3.0 μm, elongated, cylindrical, slightly broader at the center, hyaline. Sterigmata 4-8 in number. Basidiospores 3.0-4.0 × 1.5-2.0 μm, ellipsoid, greenish-white in 5% KOH, inamyloid, smooth surface and thin-walled. Cap cells and hyphae, cells 12.5-25 μm in diam, globose to subglobose, hyaline, thin-walled; hyphae 2.0-10.0 μm wide, hyaline, thin-walled, septate, branched with clamp connections. Cells of pseudostipe 15.0-67.5 μm in diam, pseudoparenchymatous, globose to a subglobose, bubble-like, hyaline, smooth surface and thin-walled. Cells of indusium 12.5-57.5 μm in diam, hyaline, globose to subglobose or bubble-like, smooth surface, thin-walled. Volva hyphae composed of two types of hyphae, type I: 2.0-2.5 μm wide, hyaline, septate, branched, smooth surface, thin-walled with clamp connections, type II: 5.0-10.0 μm wide, irregular shape, hyaline, septate, branched smooth surface and thick-walled, crystal deposits in globose to subglobose cells distributed among the hyphae. Rhizomorph hyphae are composed of two types of hyphae, type I: 2.5-5.0 μm wide, hyaline, septate, branched, smooth surface, thin-walled with clamp connections, type II: 10.0-15.0 μm wide, hyaline, branched, smooth surface, thin-walled, swollen at the tip.
Mature basidiomata 205-215 mm high. Cap campanulate, 40-50 mm high, 35-45 mm wide, surface strongly reticulate, light yellow, meshes deep, polygonal, apex with an apical pore and covered with greenish-white membrane approximately ¼ the size of the cap. Gleba moderate olive-brown, mucilaginous. Pseudostipe 158-165 mm high, cylindrical, tapering toward the apex, 20-25 mm wide at the base, 10-13 mm wide at the apex, white, fragile and soft, spongy, hollow. Indusium coarsely latticed, white, extended to ¾ the size of the pseudostipe. The meshes of indusium are large, hexagonal or polygonal, 5-10 mm wide. Volva globose to subglobose, 55 × 40 mm in diam, light brownish gray, smooth surface, Rhizomorphs white, when scratched the color changes to light purple. Odor fetid. Basidia 7.0-15.0 × 1.5-3.0 μm, elongated, cylindrical, slightly broader at the center, hyaline. Sterigmata 4-8 in number. Basidiospores 3.0-4.0 × 1.5-2.0 μm, ellipsoid, greenish-white in 5% KOH, inamyloid, smooth surface and thin-walled. Cap cells and hyphae, cells 12.5-25 μm in diam, globose to subglobose, hyaline, thin-walled; hyphae 2.0-10.0 μm wide, hyaline, thin-walled, septate, branched with clamp connections. Cells of pseudostipe 15.0-67.5 μm in diam, pseudoparenchymatous, globose to a subglobose, bubble-like, hyaline, smooth surface and thin-walled. Cells of indusium 12.5-57.5 μm in diam, hyaline, globose to subglobose or bubble-like, smooth surface, thin-walled. Volva hyphae composed of two types of hyphae, type I: 2.0-2.5 μm wide, hyaline, septate, branched, smooth surface, thin-walled with clamp connections, type II: 5.0-10.0 μm wide, irregular shape, hyaline, septate, branched smooth surface and thick-walled, crystal deposits in globose to subglobose cells distributed among the hyphae. Rhizomorph hyphae are composed of two types of hyphae, type I: 2.5-5.0 μm wide, hyaline, septate, branched, smooth surface, thin-walled with clamp connections, type II: 10.0-15.0 μm wide, hyaline, branched, smooth surface, thin-walled, swollen at the tip.
Culture characteristics:
Tissue germinated on PDA within 24 h. Colony was grown on PDA with scant mycelium, entire margin, reaching 2.0 cm in diam in 1 month at 25 °C, surface and reverse white to cream.
Colony was grown on PDA with scant mycelium, entire margin, reaching 2.0 cm in diam in 1 month at 25 °C, surface and reverse white to cream.
Reference:
Sommai S, Khamsuntorn P, Somrithipol S, et al. (2021). Phallus chiangmaiensis sp. nov. and a Record of P. merulinus in Thailand. Mycobiology 49: 439–453.
DOI: https://doi.org/10.1080/12298093.2021.1965706Species |
Strain |
Compound |
Pubchem CID |
Biological activity |
Reference |
|---|
|
Strain |
ATP6 | ITS | LSU |
|---|---|---|---|
| BCC 92054 | MT454265 | MT452882 | MT447464 |
| BCC 92055 | MT454263 | MT452883 | MT447465 |